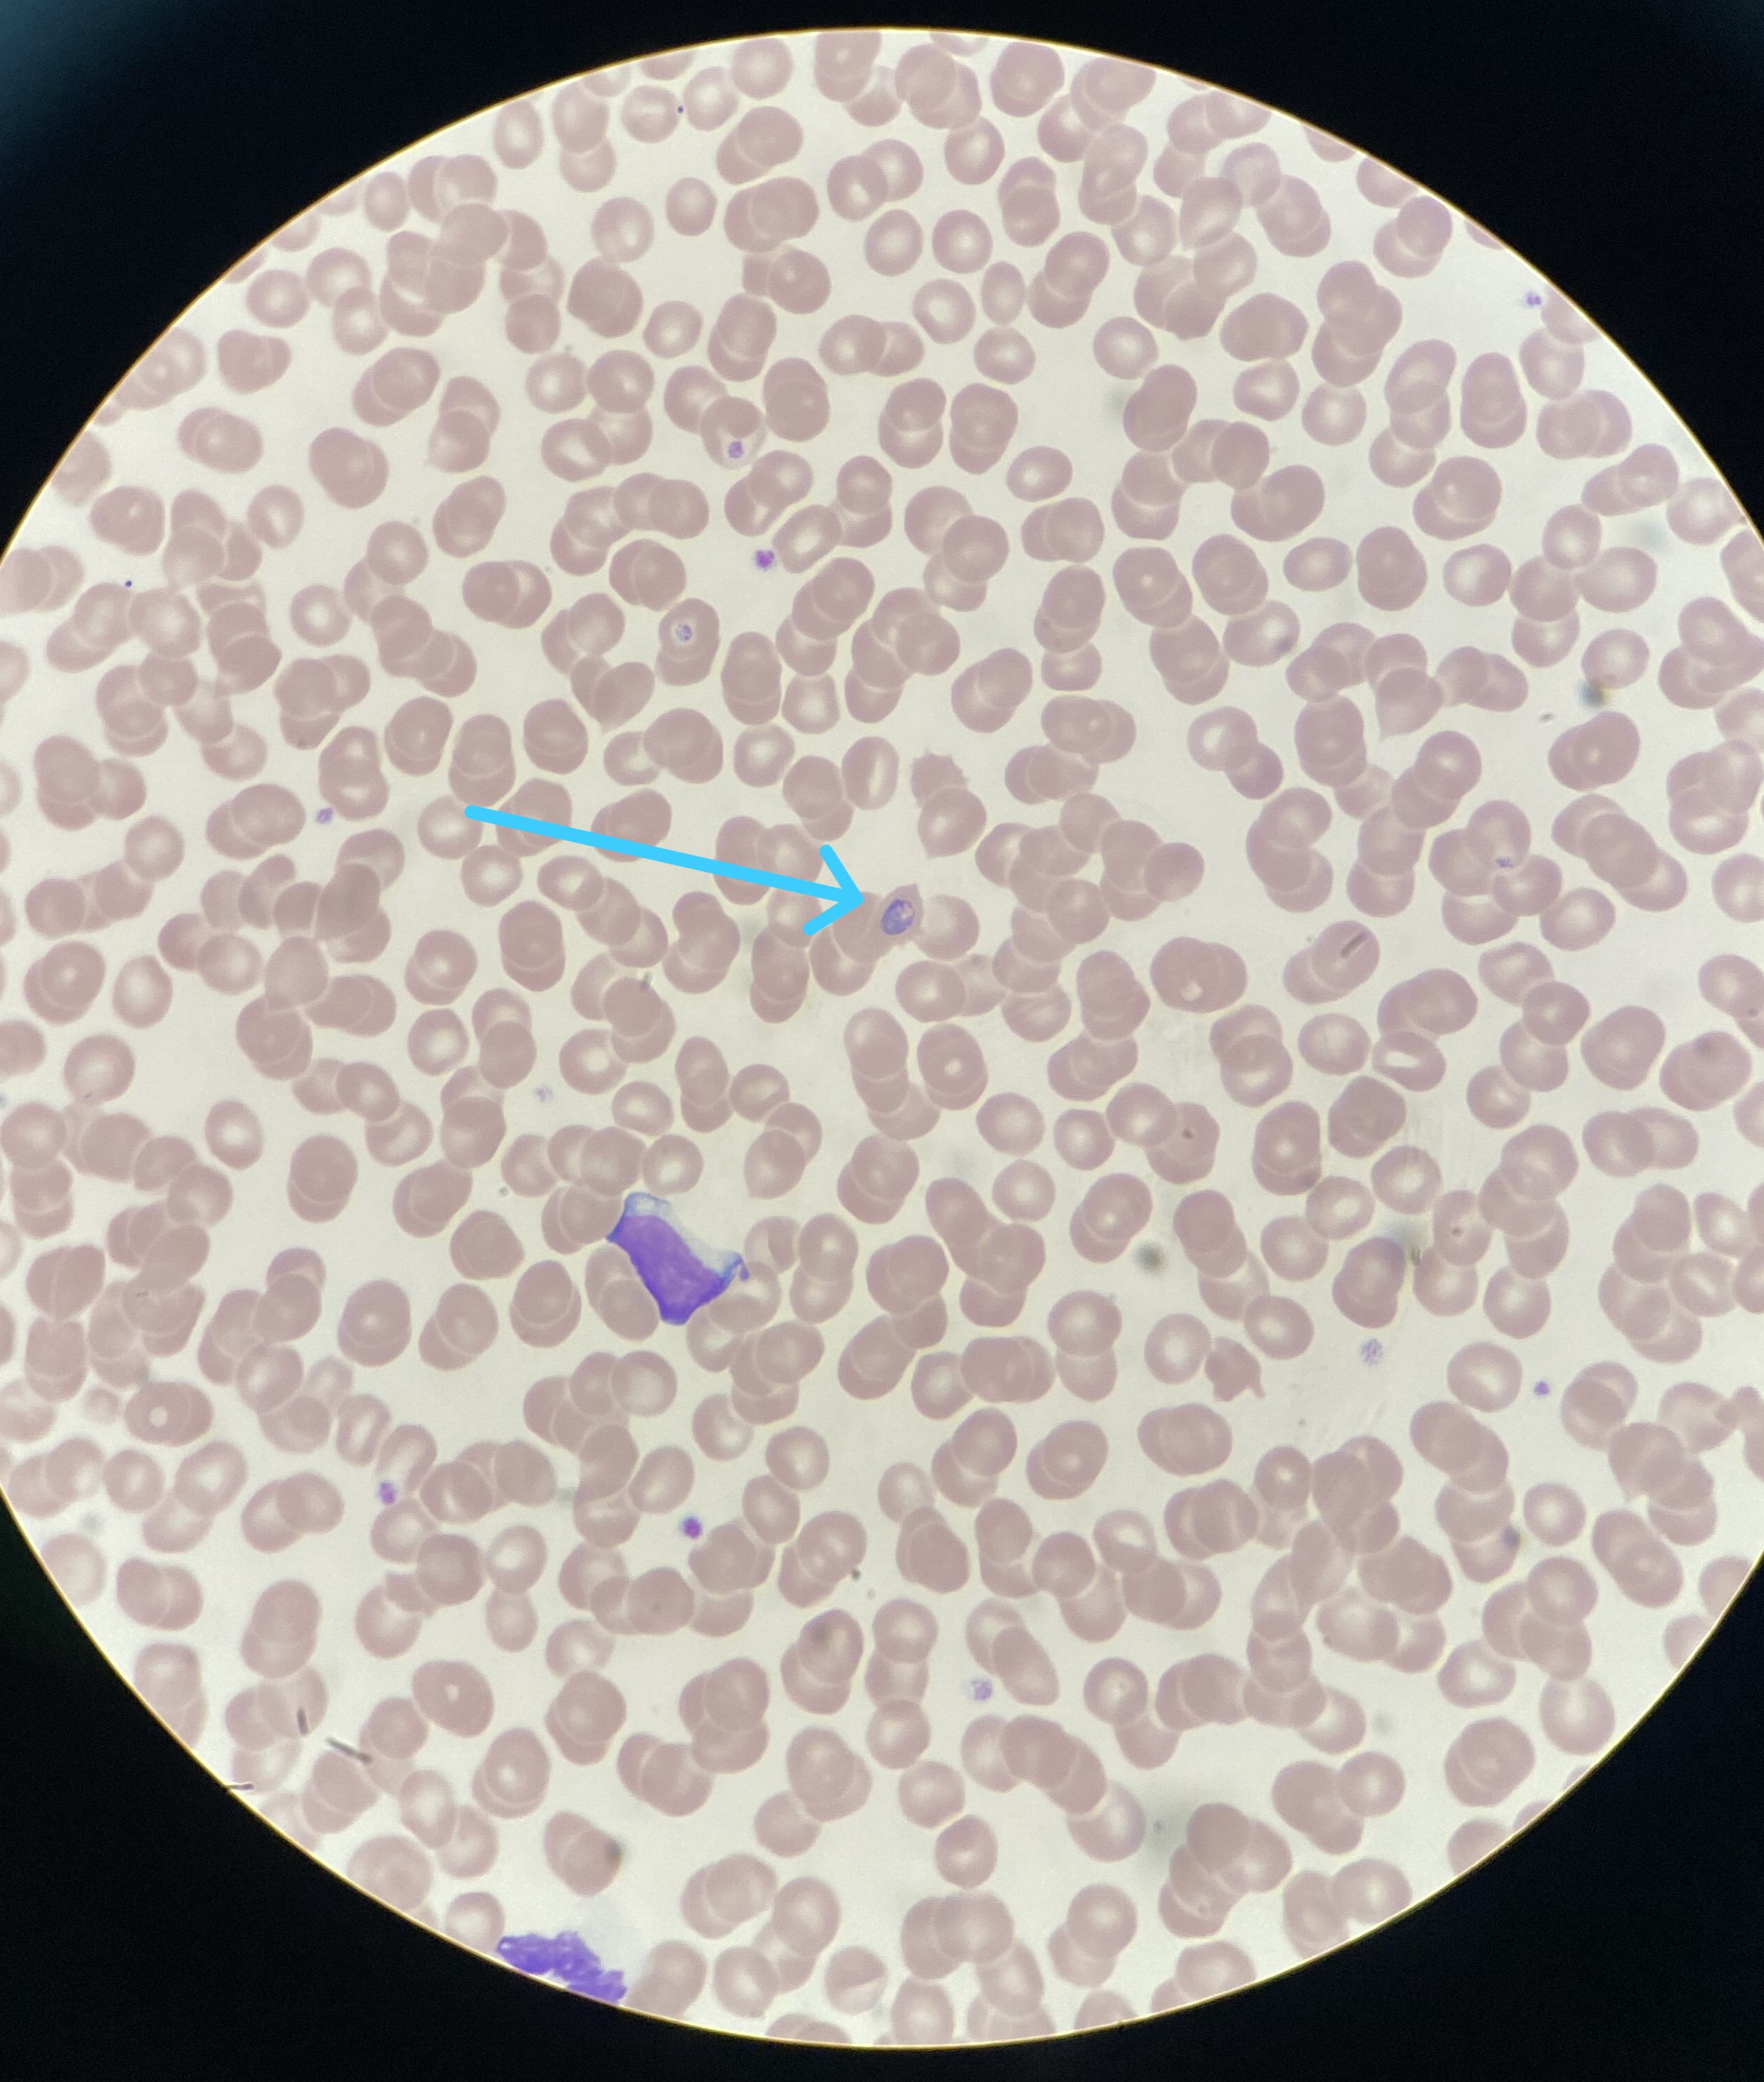

清华长庚医院2月1日电(通讯员 熊攀)近日,在形态岗值班时,一份感染科送检的血液疟原虫检查引起了临检组技师王琦的警觉。查看病史发现,患者4天前开始发热,系非洲归国人员。值班人员立即制备血涂片,染色后显微镜下仔细镜检。
镜检过程中,疑似疟原虫的形态出现在视野中,值班人员迅速报告给组长董静肖副主任技师。经过几位形态学骨干的仔细辨认,当即发出正式报告:可见疟原虫,并备注卵形疟原虫可能性大,可见滋养体期及裂殖体前期。情况紧急,值班人员立即与开单医生取得联系,详细告知这一诊断结果。为确保患者得到及时治疗,建议医生尽快联系患者并告知其立即就医。同时,遵循感控流程,样本被安全送至CDC进行复检。经过严格的复检流程,一周后CDC的检测结果回报,确认患者所患疟疾为卵形疟。这一及时的发现与诊断,得益于值班人员的专业素养和团队的紧密协作,为患者赢得了宝贵的治疗时机。

图为疟原虫滋养体 图为疟原虫裂殖体
“卵形疟”是什么?
疟疾的一种,而疟疾是寄生虫病类的传染病,传播媒介为按蚊,病原体为疟原虫,通常寄生在人体红细胞或肝细胞内。目前常见的能够感染人类的有:恶性疟、间日疟、三日疟和卵形疟。恶性疟与三日疟一般无复发,而间日疟和卵形疟有迟发性子孢子,未经规范治疗容易引起复发,复发一般6-10月内。
临床症状
疟疾的常见症状,多见周期性规律发作,全身发冷、发热、多汗,不过恶性疟的发热多不规则。长期多次发作后,可引起贫血和脾肿大。凶险型如脑型疟,可见剧烈头痛、谵妄、急性神经紊乱、高热、昏睡或昏迷、惊厥,严重时可引起死亡。

北京清华长庚医院APP
快速挂号